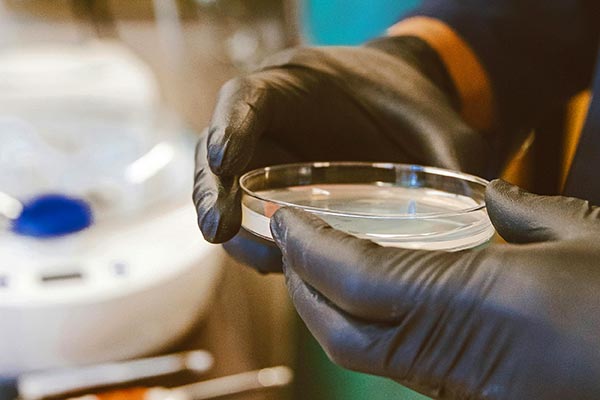
Lab test in petri-dish

Community
Meeting wide local need – from play parks and community centres, to healthy activities and veteran support

Public wellbeing
Helping keep the borough a safe, healthy and happy place through addressing key issues and concerns that matter to you

Personal wellbeing
From accessing housing benefit to eligibility for council tax support, we’re there to provide advice and guide you

Planning
From securing the right homes for future need, to planning permission for your home – we’re here to help

Living landscape
Caring for your natural and historic landscape through enforcement, guidance and careful management

Licensing and Regulation
Ensuring environmental, hygiene and public safety concerns are met all year around